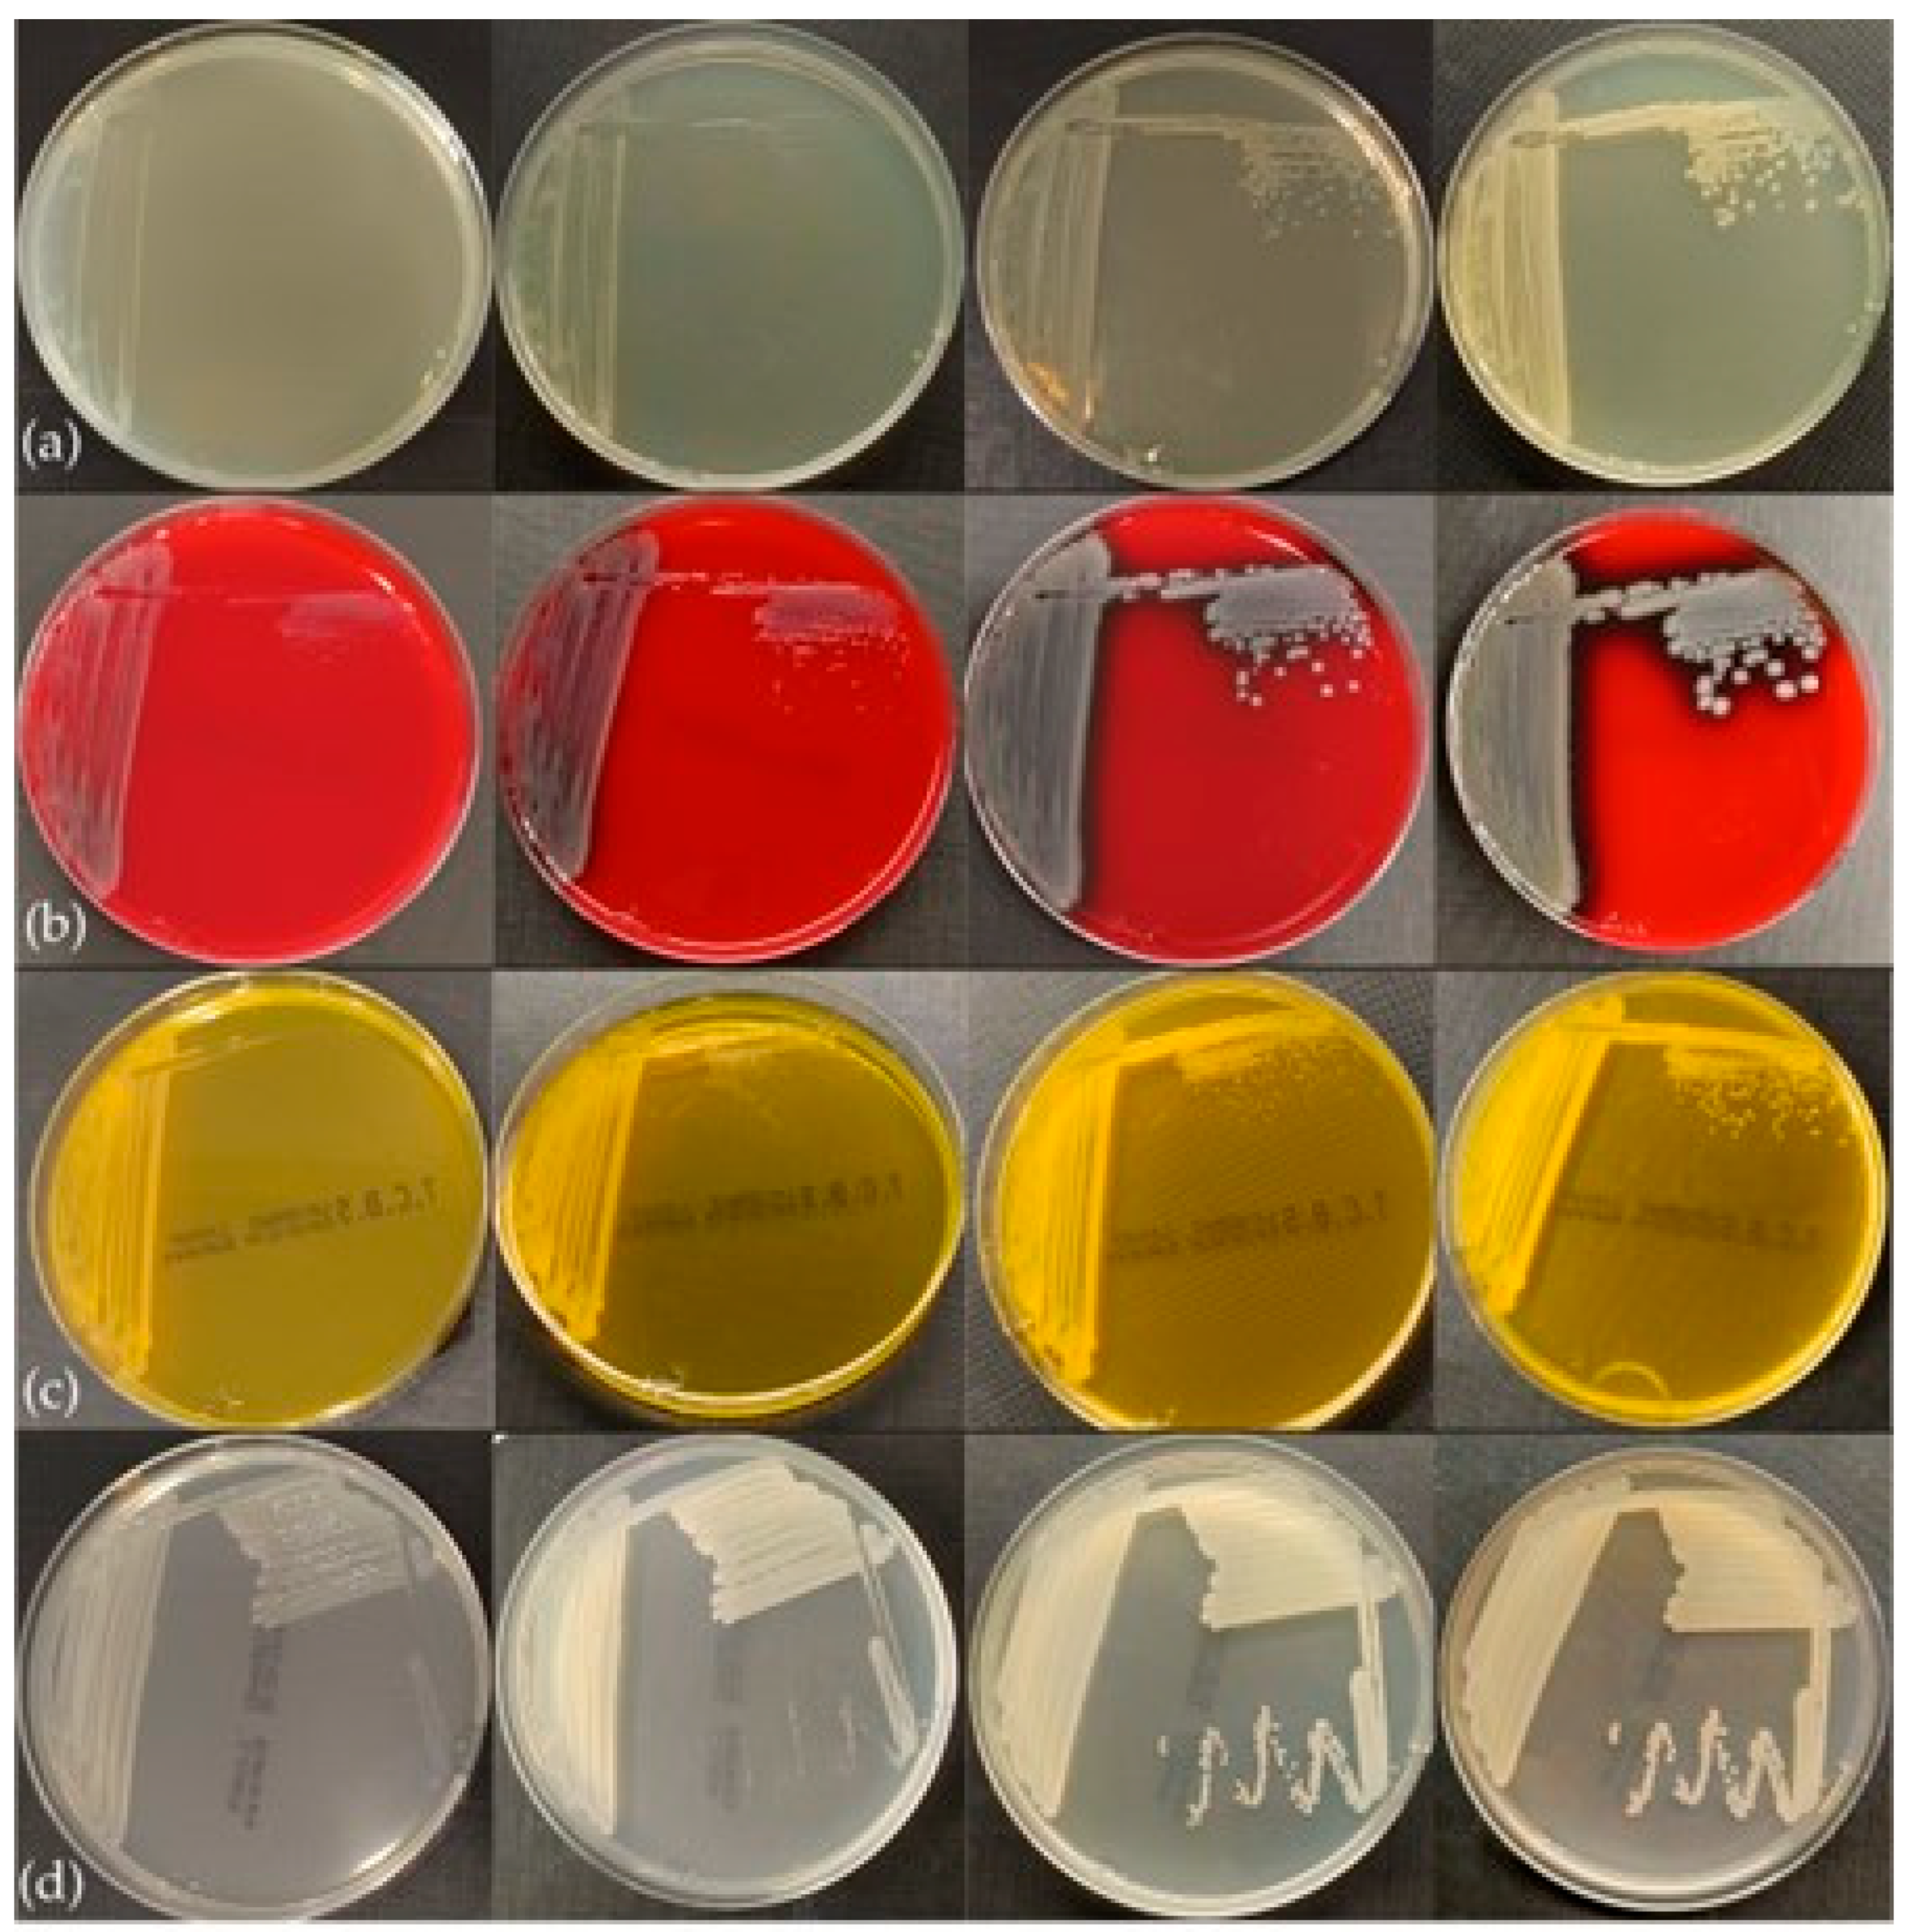

First Outbreak of Aeromoniasis, Caused by Aeromonas veronii, in Farmed European Seabass (Dicentrarchus labrax) in the Ionian Sea, Greece
Abstract
1. Introduction
2. Materials and Methods
2.1. Disease Description
2.2. Postmortem Examination
2.3. Histology
2.4. Microbiology
2.5. Biochemical Testing
2.6. Biofilm Formation Ability of Isolates
2.7. DNA Extraction and Real-Time PCR
2.8. Whole-Genome Sequencing and Data Analysis
3. Results
3.1. Gross Pathology and Microscopic Examination
3.2. Histopathology
3.3. Phenotypic Characteristics
3.4. Biochemical Profiles
3.5. Molecular Characterization
3.6. Genomic and Phylogenetic Characterization
4. Discussion
5. Conclusions
Supplementary Materials
Author Contributions
Funding
Institutional Review Board Statement
Informed Consent Statement
Data Availability Statement
Conflicts of Interest
References
- Hapo. Aquaculture Annual Report 2024. Available online: https://fishfromgreece.com/en/annual-report-2024/ (accessed on 10 February 2025).
- FAO. Fisheries and Aquaculture. 2025 National Aquaculture Sector Overview—Greece. Available online: https://www.fao.org/fishery/en/countrysector/naso_greece (accessed on 10 February 2025).
- Leung, T.L.F.; Bates, A.E. More Rapid and Severe Disease Outbreaks for Aquaculture at the Tropics: Implications for Food Security. J. Appl. Ecol. 2013, 50, 215–222. [Google Scholar] [CrossRef]
- Hegde, A.; Kabra, S.; Basawa, R.M.; Khile, D.A.; Abbu, R.U.F.; Thomas, N.A.; Manickam, N.B.; Raval, R. Bacterial diseases in marine fish species: Current trends and future prospects in disease management. World J. Microbiol. Biotechnol. 2023, 39, 317. [Google Scholar] [CrossRef] [PubMed]
- Tomás, J.M. The Main Aeromonas Pathogenic Factors. ISRN Microbiol. 2012, 2012, 256261. [Google Scholar] [CrossRef] [PubMed]
- Hoai, T.D.; Trang, T.T.; Van Tuyen, N.; Giang, N.T.H.; Van Van, K. Aeromonas veronii Caused Disease and Mortality in Channel Catfish in Vietnam. Aquaculture 2019, 513, 734425. [Google Scholar] [CrossRef]
- Ran, C.; Qin, C.; Xie, M.; Zhang, J.; Li, J.; Xie, Y.; Wang, Y.; Li, S.; Liu, L.; Fu, X. Aeromonas veronii and Aerolysin Are Important for the Pathogenesis of Motile Aeromonad Septicemia in Cyprinid Fish. Environ. Microbiol. 2018, 20, 3442–3456. [Google Scholar] [CrossRef]
- Li, F.; Wu, D.; Gu, H.R.; Yin, M.; Ge, H.L.; Liu, X.H.; Huang, J.; Zhang, Y.G.; Wang, Z.J. Aeromonas hydrophila and Aeromonas veronii Cause Motile Aeromonas Septicaemia in the Cultured Chinese Sucker, Myxocyprinus asiaticus. Aquac. Res. 2019, 50, 1515–1526. [Google Scholar] [CrossRef]
- Liu, G.; Li, J.; Jiang, Z.; Zhu, X.; Gao, X.; Jiang, Q.; Wang, J.; Wei, W.; Zhang, X. Pathogenicity of Aeromonas veronii Causing Mass Mortalities of Odontobutis potamophila and Its Induced Host Immune Response. Fish Shellfish Immunol. 2022, 125, 180–189. [Google Scholar] [CrossRef]
- Chen, F.; Sun, J.; Han, Z.; Yang, X.; Xian, J.A.A.; Lv, A.; Hu, X.; Shi, H. Isolation, Identification and Characteristics of Aeromonas veronii From Diseased Crucian Carp (Carassius auratus gibelio). Front. Microbiol. 2019, 10, 2742. [Google Scholar] [CrossRef]
- Raj, N.S.; Swaminathan, T.R.; Dharmaratnam, A.; Raja, S.A.; Ramraj, D.; Lal, K.K. Aeromonas veronii Caused Bilateral Exophthalmia and Mass Mortality in Cultured Nile Tilapia, Oreochromis niloticus (L.) in India. Aquaculture 2019, 512, 734278. [Google Scholar] [CrossRef]
- Dong, H.T.; Techatanakitarnan, C.; Jindakittikul, P.; Thaiprayoon, A.; Taengphu, S.; Charoensapsri, W.; Khunrae, P.; Rattanarojpong, T.; Senapin, S. Aeromonas jandaei and Aeromonas veronii Caused Disease and Mortality in Nile Tilapia, Oreochromis niloticus (L.). J. Fish Dis. 2017, 40, 1395–1403. [Google Scholar] [CrossRef]
- Behera, B.K.; Parida, S.N.; Kumar, V.; Swain, H.S.; Parida, P.K.; Bisai, K.; Dhar, S.; Das, B.K. Aeromonas veronii Is a Lethal Pathogen Isolated from Gut of Infected Labeo Rohita: Molecular Insight to Understand the Bacterial Virulence and Its Induced Host Immunity. Pathogens 2023, 12, 598. [Google Scholar] [CrossRef] [PubMed]
- Pei, C.; Song, H.; Zhu, L.; Qiao, D.; Yan, Y.; Li, L.; Zhao, X.; Zhang, J.; Jiang, X.; Kong, X. Identification of Aeromonas veronii Isolated from Largemouth Bass Micropterus salmoides and Histopathological Analysis. Aquaculture 2021, 540, 736707. [Google Scholar] [CrossRef]
- Liu, W.; Li, M.; Xue, M.; Zhou, Y.; Jiang, N.; Meng, Y.; Liu, Y.; Jiang, J.; Liao, X.; Fan, Y. Identification of Aeromonas veronii as the Pathogen Associated with Massive Mortality in Bronze Gudgeon (Coreius heterodon). Animals 2024, 14, 2440. [Google Scholar] [CrossRef] [PubMed]
- Cascarano, M.C.; Stavrakidis-Zachou, O.; Mladineo, I.; Thompson, K.D.; Papandroulakis, N.; Katharios, P. Mediterranean Aquaculture in a Changing Climate: Temperature Effects on Pathogens and Diseases of Three Farmed Fish Species. Pathogens 2021, 10, 1205. [Google Scholar] [CrossRef] [PubMed]
- Smyrli, M.; Prapas, A.; Rigos, G.; Kokkari, C.; Pavlidis, M.; Katharios, P. Aeromonas veronii Infection Associated with High Morbidity and Mortality in Farmed European Seabass Dicentrarchus labrax in the Aegean Sea, Greece. Fish Pathol. 2017, 52, 68–81. [Google Scholar] [CrossRef]
- Karatas, S.; Candan, A.; Demircan, D. Atypical Aeromonas Infection in Cultured Sea Bass (Dicentrarchus labrax) in the Black Sea. Isr. J. Aquacult. Bamidgeh 2005, 57, 255–263. [Google Scholar]
- Carleton, H.M.; Drury, R.A.B.; Wallington, E.A. Carleton’s Histological Technique, 5th ed.; Oxford University Press: Oxford, UK, 1980. [Google Scholar]
- Roberts, R.J. Fish Pathology; John Wiley & Sons: Hoboken, NJ, USA, 2012; ISBN 978-1-444-33282-7. [Google Scholar]
- Bauer, A.W.; Kirby, W.M.M.; Sheriss, J.C.; Turck, M. Antibiotic Susceptibility Testing by a Standardized Single Disk Method. Am. J. Clin. Pathol. 1966, 45, 493–496. [Google Scholar] [CrossRef]
- Weinstein, M.P.; Lewis, J.S. The Clinical and Laboratory Standards Institute Subcommittee on Antimicrobial Susceptibility Testing: Background, Organization, Functions, and Processes. J. Clin. Microbiol. 2020, 58, 10–1128. [Google Scholar] [CrossRef]
- Patel, J.B.; Sharp, S.; Novak- Weekley, S. Verification of Antimicrobial Susceptibility Testing Methods: A Practical Approach. Clin. Microbiol. Newsl. 2013, 35, 103–109. [Google Scholar] [CrossRef]
- Borges, A.; Saavedra, M.J.; Simões, M. The Activity of Ferulic and Gallic Acids in Biofilm Prevention and Control of Pathogenic Bacteria. Biofouling 2012, 28, 755–767. [Google Scholar] [CrossRef]
- Tatusova, T.; Dicuccio, M.; Badretdin, A.; Chetvernin, V.; Nawrocki, E.P.; Zaslavsky, L.; Lomsadze, A.; Pruitt, K.D.; Borodovsky, M.; Ostell, J. NCBI Prokaryotic Genome Annotation Pipeline. Nucleic Acids Res. 2016, 44, 6614–6624. [Google Scholar] [CrossRef] [PubMed]
- Chen, S.; Zhou, Y.; Chen, Y.; Gu, J. Fastp: An Ultra-Fast All-in-One FASTQ Preprocessor. Bioinformatics 2018, 34, i884–i890. [Google Scholar] [CrossRef]
- Souvorov, A.; Agarwala, R.; Lipman, D.J. SKESA: Strategic k-Mer Extension for Scrupulous Assemblies. Genome Biol. 2018, 19, 153. [Google Scholar] [CrossRef]
- Seemann, T. Prokka: Rapid Prokaryotic Genome Annotation. Bioinformatics 2014, 30, 2068–2069. [Google Scholar] [CrossRef]
- Larsen, M.V.; Cosentino, S.; Rasmussen, S.; Friis, C.; Hasman, H.; Marvig, R.L.; Jelsbak, L.; Sicheritz-Pontén, T.; Ussery, D.W.; Aarestrup, F.M. Multilocus Sequence Typing of Total-Genome-Sequenced Bacteria. J. Clin. Microbiol. 2012, 50, 1355–1361. [Google Scholar] [CrossRef] [PubMed]
- Liu, H.; Wang, H.; Wei, Z.; Zhang, S.; Hua, G.; Zhang, S.W.; Zhang, L.; Gao, S.J.; Meng, J.; Chen, X.; et al. MeT-DB V2.0: Elucidating Context-Specific Functions of N 6 -Methyl-Adenosine Methyltranscriptome. Nucleic Acids Res. 2018, 46, D281–D287. [Google Scholar] [CrossRef] [PubMed]
- Jain, C.; Rodriguez-R, L.M.; Phillippy, A.M.; Konstantinidis, K.T.; Aluru, S. High Throughput ANI Analysis of 90K Prokaryotic Genomes Reveals Clear Species Boundaries. Nat. Commun. 2018, 9, 5114. [Google Scholar] [CrossRef]
- Smyrli, M.; Triga, A.; Dourala, N.; Varvarigos, P.; Pavlidis, M.; Quoc, V.H.; Katharios, P. Comparative Study on a Novel Pathogen of European Seabass. Diversity of Aeromonas veronii in the Aegean Sea. Microorganisms 2019, 7, 504. [Google Scholar] [CrossRef]
- Sievers, F.; Wilm, A.; Dineen, D.; Gibson, T.J.; Karplus, K.; Li, W.; Lopez, R.; McWilliam, H.; Remmert, M.; Söding, J. Fast, Scalable Generation of High-Quality Protein Multiple Sequence Alignments Using Clustal Omega. Mol. Syst. Biol. 2011, 7, 539. [Google Scholar] [CrossRef]
- Tanrıkul, T.T.; Dinçtürk, E. A New Outbreak in Sea Bass Farming in Turkey: Aeromonas veronii. J. Hell. Vet. Med. Soc. 2021, 72, 3051–3058. [Google Scholar] [CrossRef]
- Rahman, M.T.; Sobur, M.A.; Islam, M.S.; Ievy, S.; Hossain, M.J.; Zowalaty, M.E.E.; Rahman, A.M.M.T.; Ashour, H.M. Zoonotic Diseases: Etiology, Impact, and Control. Microorganisms 2020, 8, 1405. [Google Scholar] [CrossRef]
- Uzun Yaylacı, E.U.; Öǧüt, H. The Isolation Frequency of Bacterial Pathogens from Sea Bass (Dicentrarchus labrax) in the Southeastern Black Sea. Aquaculture 2015, 437, 30–37. [Google Scholar] [CrossRef]
- Yu, J.; Han, J.-J.; Kim, H.; Kang, S.-G.; Park, S.-W. First Report of Aeromonas veronii Infection in Farmed Israeli Carp Cyprinus Carpio in Korea. J. Fish Pathol. 2010, 23, 165–176. [Google Scholar]
- Zheng, W.; Cao, H.; Yang, X. Aeromonas veronii Infection in the Cultured Snakehead Fish, Ophiocephalus argus (Cantor). Afr. J. Microbiol. Res. 2012, 6, 7218–7223. Available online: https://academicjournals.org/journal/AJMR/article-full-text-pdf/9BD5DC517792 (accessed on 10 June 2025).
- Wang, B.; Hu, J.; Feng, J.; Zhang, Y.; Sun, Y.; Jiang, B.; Li, W.; Liu, C.; Huang, Y.; Su, Y. Acute Septicemia and Immune Response of Spotted Sea Bass (Lateolabrax maculatus) to Aeromonas veronii Infection. Fish Shellfish Immunol. 2022, 124, 47–55. [Google Scholar] [CrossRef]
- Doukas, V.; Athanassopoulou, F.; Karagouni, E.; Dotsika, E. Aeromonas hydrophila Infection in Cultured Sea Bass, Dicentrarchus labrax L., and Puntazzo puntazzo Cuvier from the Aegean Sea. J. Fish Dis. 1998, 21, 317–320. [Google Scholar] [CrossRef]
- Fernández-Álvarez, C.; Gijón, D.; Álvarez, M.; Santos, Y. First Isolation of Aeromonas salmonicida Subspecies Salmonicida from Diseased Sea Bass, Dicentrarchus labrax (L.), Cultured in Spain. Aquac. Rep. 2016, 4, 36–41. [Google Scholar] [CrossRef]
- Real Valcárcel, F. Aeromonas salmonicida Infection in Sparus aurata in the Canaries. Bull. Eur. Assoc. Fish Pathol. 1994, 14, 153–155. [Google Scholar]
- Karatas, S.; Turgay, E.; Yardimci, R.E.; Steinum, T.M. Aeromonas veronii biovar veronii Infection in Cultured European Seabass (Dicentrarchus labrax) in Turkiye. KSU J. Agric. Nat. 2023, 26, 1397–1404. [Google Scholar] [CrossRef]
- Abbott, S.L.; Cheung, W.K.W.; Janda, J.M. The Genus Aeromonas: Biochemical Characteristics, Atypical Reactions, and Phenotypic Identification Schemes. J. Clin. Microbiol. 2003, 41, 2348–2357. [Google Scholar] [CrossRef]
- Austin, B. Taxonomy of Bacterial Fish Pathogens. Vet. Res. 2011, 42, 20. [Google Scholar] [CrossRef]
- Janda, J.M.; Abbott, S.L. The Genus Aeromonas: Taxonomy, Pathogenicity, and Infection. Clin. Microbiol. Rev. 2010, 23, 35–73. [Google Scholar] [CrossRef] [PubMed]
- Noga, E.J. Fish Disease: Diagnosis and Treatment; John Wiley & Sons: New York, NY, USA, 2011. [Google Scholar]
- Wang, B.; Mao, C.; Feng, J.; Li, Y.; Hu, J.; Jiang, B.; Gu, Q.; Su, Y. A First Report of Aeromonas veronii Infection of the Sea Bass, Lateolabrax maculatus in China. Front. Vet. Sci. 2021, 7, 600587. [Google Scholar] [CrossRef] [PubMed]
- Bari, S.M.; Islam, M.M.; Amina, A.; Khatun, M.; Shahabuddin, A.M. Molecular Identification, Histopathology and Antibiotic Susceptibility Profiling of Aeromonas veronii Isolated from Oreochromis niloticus in Bangladesh. Vet. Med. Sci. 2024, 10, e70103. [Google Scholar] [CrossRef] [PubMed]
- Beaz-Hidalgo, R.; Figueras, M.J. Aeromonas spp. Whole Genomes and Virulence Factors Implicated in Fish Disease. J. Fish Dis. 2013, 36, 371–388. [Google Scholar] [CrossRef]
- El-Hossary, D.; Mahdy, A.; Elariny, E.Y.T.; Askora, A.; Merwad, A.M.A.; Saber, T.; Dahshan, H.; Hakami, N.Y.; Ibrahim, R.A. Antibiotic Resistance, Virulence Gene Detection, and Biofilm Formation in Aeromonas spp. Isolated from Fish and Humans in Egypt. Biology 2023, 12, 421. [Google Scholar] [CrossRef]
- Dias, C.; Borges, A.; Saavedra, M.J.; Simões, M. Biofilm Formation and Multidrug-Resistant Aeromonas spp. from Wild Animals. J. Glob. Antimicrob. Resist. 2018, 12, 227–234. [Google Scholar] [CrossRef]

| Region | Fish Farms (Identification Number) | Necropsy 1 | Histology 1 | Cultures 1 | Antimicrobial Susceptibility Tests 2 | Biochemical Identification 2 | Biofilm Formation Ability 2 | Real-Time PCR (Colonies) | Real-Time PCR (Pooled Spleens) | Whole Genome Sequencing 2 |
|---|---|---|---|---|---|---|---|---|---|---|
| Thesprotia | #1 | 94 | 3 | 94 | 15 | 1 | 1 | 4 | 7 | 1 |
| #2 | 80 | 3 | 80 | 13 | 1 | 1 | 3 | 3 | - | |
| #3 | 66 | 3 | 66 | 11 | 1 | 1 | 3 | 2 | - | |
| #4 | 78 | 4 | 78 | 13 | - | 1 | 3 | 3 | - | |
| #5 | 68 | 3 | 68 | 11 | - | 1 | 2 | 2 | - | |
| #6 | 82 | 3 | 82 | 12 | - | 1 | 2 | 2 | - | |
| Aetoloakarnania | #1 | 56 | 3 | 56 | 9 | 1 | 1 | 4 | 4 | 1 |
| Total | 7 | 524 | 22 | 524 | 84 | 4 | 7 | 21 | 23 | 2 |
| Region | Isolates | Antimicrobial Resistance Profiles a | Biofilm b,c | Motility | Pigmentation c | |||||||
|---|---|---|---|---|---|---|---|---|---|---|---|---|
| OA | DO | OT | SXT | FFC | UB | ODc | OD | Formation Ability c | ||||
| Ionian Sea | Thesp1 | S | I | S | R | S | S | 0.052 | 0.038 | NB | + | − |
| Thesp2 | I | I | I | I | S | S | 0.052 | 0.041 | NB | + | − | |
| Thesp3 | I | I | I | I | S | S | 0.052 | 0.045 | NB | + | − | |
| Thesp4 | I | I | I | I | S | S | 0.052 | 0.040 | NB | + | − | |
| Thesp5 | I | I | I | I | S | S | 0.052 | 0.040 | NB | + | − | |
| Thesp6 | I | I | I | I | S | S | 0.052 | 0.035 | NB | + | − | |
| Aetol1 | S | S | S | S | S | S | 0.052 | 0.043 | NB | + | − | |
| East Aegean Sea | AG 5.28.6 | S | S | S | S | S | S | ND | ND | ND | + | ND |
| BIOO50A | S | S | S | S | S | S | ND | ND | ND | + | ND | |
| West Aegean Sea | NS13 | S | S | S | S | S | S | ND | ND | ND | − | − |
| PDB | S | S | S | S | S | S | ND | ND | ND | + | + | |
| NS | S | S | S | S | S | S | ND | ND | ND | − | − | |
Disclaimer/Publisher’s Note: The statements, opinions and data contained in all publications are solely those of the individual author(s) and contributor(s) and not of MDPI and/or the editor(s). MDPI and/or the editor(s) disclaim responsibility for any injury to people or property resulting from any ideas, methods, instructions or products referred to in the content. |
© 2025 by the authors. Licensee MDPI, Basel, Switzerland. This article is an open access article distributed under the terms and conditions of the Creative Commons Attribution (CC BY) license (https://creativecommons.org/licenses/by/4.0/).
Share and Cite
Lampou, E.; Psychari, E.; Louka, K.; Kotzamanidis, C.; Malousi, A.; Petropoulos, I.; Kolygas, M.N.; Doukas, D.; Bitchava, K. First Outbreak of Aeromoniasis, Caused by Aeromonas veronii, in Farmed European Seabass (Dicentrarchus labrax) in the Ionian Sea, Greece. Pathogens 2025, 14, 587. https://doi.org/10.3390/pathogens14060587
Lampou E, Psychari E, Louka K, Kotzamanidis C, Malousi A, Petropoulos I, Kolygas MN, Doukas D, Bitchava K. First Outbreak of Aeromoniasis, Caused by Aeromonas veronii, in Farmed European Seabass (Dicentrarchus labrax) in the Ionian Sea, Greece. Pathogens. 2025; 14(6):587. https://doi.org/10.3390/pathogens14060587
Chicago/Turabian StyleLampou, Eirini, Eleni Psychari, Konstantina Louka, Charalampos Kotzamanidis, Andigoni Malousi, Ioannis Petropoulos, Markos N. Kolygas, Dimitrios Doukas, and Konstantina Bitchava. 2025. "First Outbreak of Aeromoniasis, Caused by Aeromonas veronii, in Farmed European Seabass (Dicentrarchus labrax) in the Ionian Sea, Greece" Pathogens 14, no. 6: 587. https://doi.org/10.3390/pathogens14060587
APA StyleLampou, E., Psychari, E., Louka, K., Kotzamanidis, C., Malousi, A., Petropoulos, I., Kolygas, M. N., Doukas, D., & Bitchava, K. (2025). First Outbreak of Aeromoniasis, Caused by Aeromonas veronii, in Farmed European Seabass (Dicentrarchus labrax) in the Ionian Sea, Greece. Pathogens, 14(6), 587. https://doi.org/10.3390/pathogens14060587

